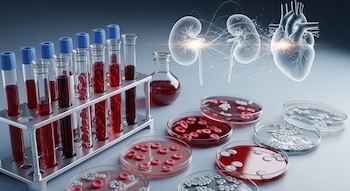
El hallazgo condujo al descubrimiento

En un laboratorio de Texas, un grupo de científicos observó a un ratón con una peculiaridad notable: presentaba niveles sorprendentemente bajos de colesterol en la sangre, mientras sus células hepáticas acumulaban grasa. Así se inició una investigación que llevó a descubrir un mecanismo biológico hasta ahora desconocido: la proteína HELZ2 puede modular la cantidad de colesterol que circula por el organismo. Este hallazgo redefine las posibilidades de tratamiento para la enfermedad cardiovascular y el hígado graso.
El equipo dirigido por Zhao Zhang, profesor asistente del Centro para la Genética de la Defensa del Huésped y de Medicina Interna de UT Southwestern Medical Center, detectó que la proteína HELZ2 actúa como un regulador central en la liberación de lipoproteínas que transportan colesterol y triglicéridos desde el hígado hacia la sangre. “Lo que encontramos es que HELZ2 funciona como un potente punto de control sobre cuántas partículas transportadoras de colesterol acaban en el torrente sanguíneo”, explicó Zhang.
El estudio, publicado en la revista Circulation, detalló que HELZ2 controla la vida útil del ARN mensajero del gen APOB, esencial para la fabricación de proteínas apoB. Estas proteínas, a su vez, conforman las partículas responsables de transportar el colesterol sanguíneo.
Cómo funciona el “interruptor” del colesterol en el hígado
El funcionamiento del sistema es preciso. Cuando la actividad de HELZ2 aumenta, reduce la estabilidad del ARN mensajero del gen APOB en las células hepáticas. Como resultado, se produce menos proteína apoB y, en consecuencia, disminuye la cantidad de lipoproteínas liberadas al torrente sanguíneo. De acuerdo con la investigación, este proceso limita la acumulación de placas en las arterias, asociada al desarrollo de aterosclerosis.
La investigadora Yiao Jiang, posdoctorada en el laboratorio de Zhang y coautora del trabajo, subrayó el aspecto innovador del hallazgo. “La mayoría de los estudios previos se centraron en qué ocurría con la apoB después de su síntesis. Lo inesperado fue descubrir que HELZ2 actúa mucho antes, regulando directamente la duración del ‘mensaje’ genético antes de que la proteína siquiera exista”, destacó Jiang.
Un experimento que revela un delicado equilibrio
La investigación utilizó una técnica de cribado genético a gran escala desarrollada por el Nobel Bruce Beutler, director del mismo centro universitario. Al analizar ratones con una variante hiperactiva de HELZ2, los científicos observaron una caída en la producción de lipoproteínas —incluido el colesterol LDL (“malo”) y los triglicéridos— en sangre, mientras se incrementaba la cantidad de grasa almacenada en el hígado.

“HELZ2 se comporta como un dial entre el hígado y la sangre. Si se incrementa su actividad, el colesterol sanguíneo baja, pero la grasa hepática sube. Si se reduce, sucede lo contrario. Esa dinámica convierte a HELZ2 en un objetivo especialmente interesante para desarrollar nuevos tratamientos”, aseguró Zhang en el reporte.
Hoy en día, los medicamentos más utilizados para reducir el colesterol son las estatinas, que actúan una vez que las partículas de colesterol ya circulan por el organismo. El descubrimiento del papel de HELZ2 abre la posibilidad de diseñar terapias que intervengan antes, a nivel del ARN, para bloquear la producción de partículas dañinas antes de que ingresen al torrente sanguíneo.

“La posibilidad de controlar la apoB desde el ARN muestra un cambio radical en la concepción de la regulación del colesterol. Nos da una nueva palanca molecular y, potencialmente, una nueva clase de herramientas para combatir estas enfermedades”, sostuvo Zhang.
Además, el equipo sugiere que una modulación precisa de HELZ2 podría ayudar a tratar tanto la aterosclerosis como el hígado graso, dos condiciones de alta prevalencia y con escasas alternativas terapéuticas innovadoras.
El trabajo representa un avance en la comprensión de los mecanismos moleculares que controlan el metabolismo del colesterol y de la grasa hepática, y sugiere nuevas líneas de investigación para el desarrollo de tratamientos personalizados.
Últimas Noticias
El ruido rosa podría interferir con un sueño saludable, concluye un ensayo
Healthday Spanish

Los alimentos ultraprocesados podrían acortar la vida de los supervivientes de cáncer
Healthday Spanish

El vínculo temprano con el padre podría afectar la salud de un niño años después, según un estudio
Healthday Spanish

Una píldora puede reducir los sofocos en pacientes con cáncer de próstata
Healthday Spanish

La mayoría de los adolescentes con SII superan los síntomas en la edad adulta, según un estudio
Healthday Spanish




